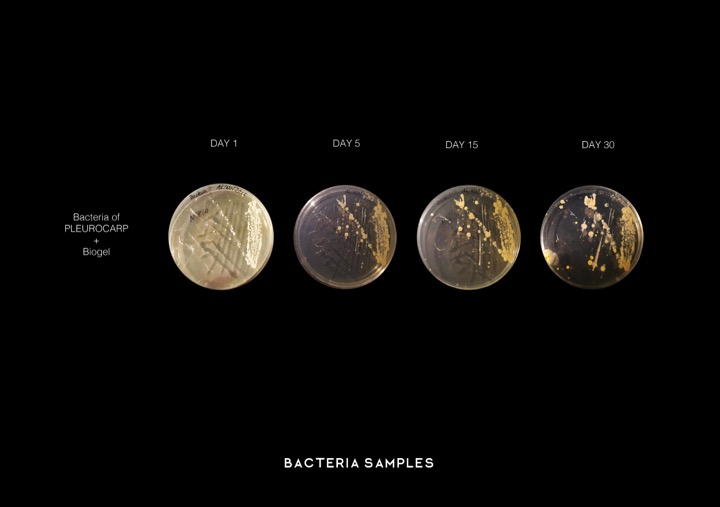
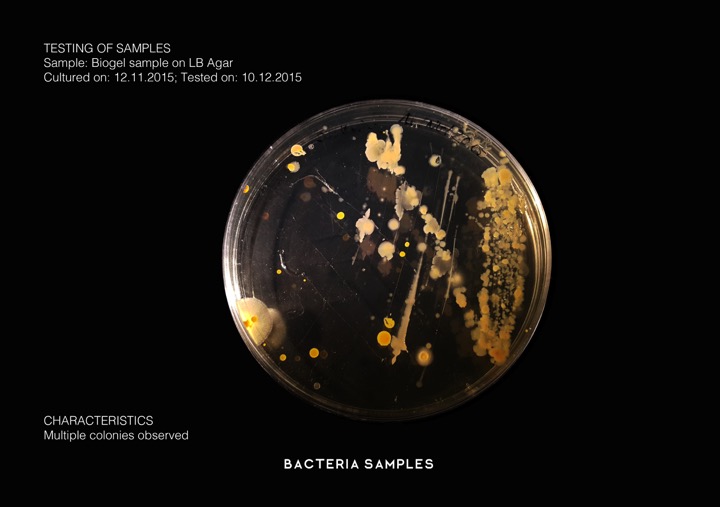

Electromoss is a project of IaaC, Institute for Advanced Architecture of Catalonia developed at the Master in advance architecture in 2015/2017 by:
Students: Carlos Daniel Gómez, Anastasia Marcella, Fabio Menezes, Monika Koeva, Sahana Sridhar, Fernando Baptista
Faculty: Claudia Pasquero, Carmelo Zappulla, Maria Kuptsova